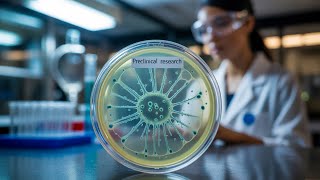

Shared 6 months ago
7 views
Shared 4 months ago
3 views
Shared 4 months ago
11 views
Shared 7 months ago
144 views
Shared 6 months ago
100 views
Shared 4 months ago
58 views
Shared 6 months ago
235 views
Shared 1 month ago
21 views
Shared 1 month ago
72 views
Shared 2 months ago
3 views
Shared 3 months ago
77 views
Shared 3 months ago
354 views
Shared 8 months ago
46 views
Shared 1 year ago
172 views
Shared 5 months ago
95 views
Shared 8 months ago
73 views
What it really means to build healthy animal facilities for preclinical studies | Dr. Madhav Marathe
Shared 8 months ago
9 views
Shared 1 year ago
28 views
Shared 1 month ago
1 view
Shared 2 months ago
7 views
Shared 2 months ago
24 views
Shared 4 months ago
97 views
Shared 1 year ago
88 views
Shared 4 months ago
8 views
Shared 4 months ago
41 views
Shared 6 months ago
59 views
Shared 1 year ago
61 views